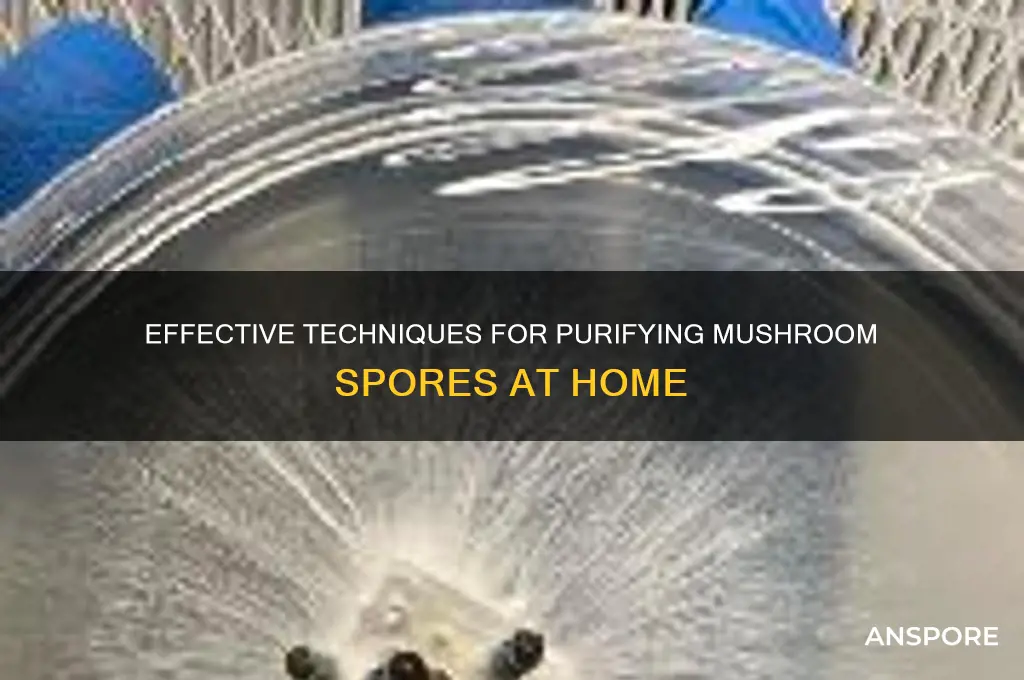
how to purify spores from mushrooms

Purifying spores from mushrooms is a critical process for mycologists, hobbyists, and researchers seeking to cultivate specific fungal species or study their genetic characteristics. The process involves isolating spores from the mushroom's cap, typically by placing it on a sterile surface or in a container, allowing the spores to naturally drop or be gently dislodged. Once collected, the spores are suspended in a sterile solution, such as distilled water, and filtered to remove contaminants like debris or bacteria. Techniques like dilution, centrifugation, or the use of fine-mesh filters may be employed to ensure purity. The resulting spore suspension can then be used for inoculation, storage, or further analysis, providing a reliable foundation for mushroom cultivation or scientific investigation.
| Characteristics | Values |
|---|---|
| Method | Sterile technique, spore printing, or spore syringe preparation |
| Materials | Mushroom cap, sterile scalpel, sterile glass slide, sterile petri dish, agar medium, sterile syringe, sterile water, bleach solution, alcohol |
| Steps | 1. Sterilize all equipment. 2. Clean mushroom cap with bleach solution and alcohol. 3. Place cap gill-side down on sterile glass slide (spore printing) or scrape gills into sterile water (spore syringe). 4. Incubate spore print on agar medium or mix spore suspension with agar. 5. Observe for contamination and isolate pure spore colonies. |
| Sterilization | 10% bleach solution, 70% ethanol, autoclaving equipment |
| Incubation | 22-28°C (72-82°F), 7-14 days |
| Agar Medium | Potato dextrose agar (PDA), malt extract agar (MEA), or nutrient agar |
| Contamination Check | Regular inspection for mold, bacteria, or other fungi |
| Storage | Store purified spores in sterile water or on agar slants at 4°C (39°F) |
| Yield | Varies by mushroom species and method, typically millions of spores per print or syringe |
| Applications | Cultivation, research, and preservation of mushroom species |
| Safety | Work in a sterile environment, wear gloves and mask, avoid inhaling spores |
| Legal Considerations | Check local regulations regarding mushroom spore collection and cultivation |
Explore related products
What You'll Learn
- Sterile Techniques: Maintain cleanliness to prevent contamination during spore collection and storage
- Spore Print Method: Harvest spores by capturing them from mushroom caps on paper
- Water Suspension: Dissolve spores in water for easy storage or microscopy
- Filtration Process: Use filters to remove debris and isolate pure spores
- Chemical Treatment: Apply sterilizing agents to eliminate bacteria and fungi from spore samples

Sterile Techniques: Maintain cleanliness to prevent contamination during spore collection and storage
Maintaining sterile techniques is paramount when purifying spores from mushrooms, as contamination can render the entire process futile. The first step in ensuring cleanliness is to create a controlled environment. Work in a clean, designated area, preferably a laminar flow hood or a still-air box, which helps minimize airborne particles. If such equipment is unavailable, choose a room with minimal traffic and ensure all surfaces are thoroughly cleaned with a disinfectant, such as 70% isopropyl alcohol or a 10% bleach solution. Allow the area to dry completely before beginning the process to avoid any residual moisture that could introduce contaminants.
Personal hygiene is equally critical in maintaining sterility. Before handling any materials, wash your hands thoroughly with antibacterial soap and wear sterile gloves. Additionally, consider wearing a lab coat or clean clothing to minimize shedding of skin cells and fibers. A face mask should also be worn to prevent respiratory particles from contaminating the workspace. All tools and containers used in the process, such as scalpels, Petri dishes, and syringes, must be sterilized using an autoclave or by soaking in alcohol before use.
During spore collection, it is essential to work with mature mushroom caps that have fully opened gills, as these contain the highest concentration of spores. Carefully cut the cap from the stem using a sterilized scalpel, ensuring the tool does not come into contact with any non-sterile surfaces. Place the cap gills-down onto a sterile surface, such as a Petri dish lined with a sterile agar medium or a piece of aluminum foil. Allow the spores to naturally drop onto the surface, avoiding any physical contact that could introduce contaminants.
Once the spores have been collected, proper storage is crucial to maintain their purity. Transfer the spores into a sterile container, such as a glass vial with a rubber septum, using a sterilized tool like a inoculation loop or syringe. Seal the container tightly and label it with the date and mushroom species. Store the spores in a cool, dark place, such as a refrigerator, to prolong their viability. Regularly inspect the storage area for any signs of contamination, such as mold growth, and discard any compromised samples immediately.
Finally, documentation and organization are key components of sterile techniques. Keep a detailed record of each step in the process, including the date, materials used, and any observations. This not only helps in replicating successful procedures but also in identifying potential sources of contamination. Organize your workspace and materials systematically, ensuring that sterile and non-sterile items are clearly separated to prevent cross-contamination. By adhering to these rigorous sterile techniques, you can significantly reduce the risk of contamination and ensure the successful purification and storage of mushroom spores.
Decoding Nature's Mystery: What Does a Circle of White Mushrooms Mean?
You may want to see also

Spore Print Method: Harvest spores by capturing them from mushroom caps on paper
The Spore Print Method is a simple and effective technique for harvesting spores from mushrooms, allowing you to capture and preserve the genetic material for cultivation or study. This method involves placing a mature mushroom cap on a piece of paper to collect the spores released from the gills or pores underneath. To begin, select a healthy, fully mature mushroom with an open cap, ensuring it is free from contamination. Gently twist or cut the stem to separate the cap from the stipe, taking care not to damage the delicate gill structure.
Prepare your workspace by gathering a clean, dry piece of paper, preferably white or black to provide contrast for visibility. Glass or aluminum foil can also be used, but paper is the most common and accessible option. Place the mushroom cap gills-down onto the center of the paper, ensuring it makes full contact with the surface. To create a humid environment that encourages spore release, cover the mushroom cap with a glass or jar, being careful not to disturb the cap's position. Leave the setup undisturbed in a clean area for several hours to overnight, allowing the spores to naturally drop onto the paper.
After the waiting period, slowly and carefully remove the glass and then the mushroom cap, ensuring no spores are dislodged in the process. You should see a distinct spore print pattern on the paper, mirroring the shape of the mushroom cap. The color and density of the spore print will vary depending on the mushroom species. At this stage, the spores are still exposed and need to be handled carefully to avoid contamination. Allow the spore print to dry completely before attempting to collect or store the spores.
Once dry, the spore print can be carefully folded or scraped to collect the spores into a sterile container. To purify the spores further, you can dissolve the paper in a small amount of sterile water or a weak bleach solution (for darker spores on white paper), then filter and rinse the spores to remove any paper residue. Alternatively, for lighter spores on dark paper, gently scrape the spores into a container without using liquid. Properly label and store the purified spores in a cool, dark place until ready for use in cultivation or experimentation.
For long-term storage, consider placing the spores in a vial or envelope within an airtight container with desiccant to prevent moisture absorption. This method ensures the spores remain viable for extended periods. The Spore Print Method is not only a practical way to harvest spores but also an engaging process that deepens your understanding of fungal biology. With patience and attention to detail, you can successfully purify and preserve mushroom spores for various applications.
Fresh or Frozen: Red Lobster's Stuffed Mushrooms
You may want to see also

Water Suspension: Dissolve spores in water for easy storage or microscopy
Water suspension is a straightforward and effective method for storing or preparing mushroom spores for microscopy. The process involves dissolving spores in water, creating a stable solution that can be easily stored or used for observation. To begin, you’ll need a few basic supplies: sterile distilled water, a sterile container, a sterile syringe or dropper, and, of course, your spore sample. Ensure all equipment is properly sterilized to prevent contamination, as even minor impurities can compromise the suspension. Start by preparing your spore sample, which can be obtained from a spore print or spore syringe. If using a spore print, gently scrape the spores into a sterile container using a sterile scalpel or needle.
Once your spore sample is ready, carefully transfer it into a sterile container filled with a small amount of distilled water. The amount of water used depends on the desired concentration of the suspension, but typically, 10–20 milliliters of water is sufficient for most applications. Use a sterile syringe or dropper to mix the spores gently into the water, ensuring they are evenly distributed. Avoid vigorous shaking or stirring, as this can damage the spores. The goal is to create a homogeneous suspension where the spores remain suspended in the water without clumping. This mixture is now ready for storage or immediate use in microscopy.
For long-term storage, transfer the spore suspension into a sterile, airtight container, such as a glass vial with a secure lid or a sealed syringe. Label the container with the date and spore species for future reference. Store the suspension in a cool, dark place, such as a refrigerator, to maintain its viability. Properly stored, a water suspension can remain viable for several months to a year, depending on the species and storage conditions. This method is particularly useful for hobbyists and researchers who need to preserve spores for extended periods without the complexity of more advanced storage techniques.
When preparing the suspension for microscopy, ensure your workspace and equipment are clean and sterile to avoid contamination. Place a small drop of the spore suspension on a microscope slide using a sterile dropper or pipette. Cover the drop with a coverslip, taking care to avoid trapping air bubbles, which can interfere with observation. The water suspension allows for clear and detailed examination of the spores under a microscope, making it an ideal method for educational or research purposes. This technique is especially valuable for beginners, as it requires minimal specialized equipment and is relatively easy to master.
In summary, water suspension is a simple yet effective way to dissolve mushroom spores in water for storage or microscopy. By following sterile techniques and using the right materials, you can create a stable suspension that preserves spore viability and facilitates detailed observation. Whether you’re a hobbyist, researcher, or educator, this method offers a practical solution for working with mushroom spores in a controlled and accessible manner. With proper care, your spore suspension will serve as a reliable resource for future studies or experiments.
Mushroom Mystery: Do They Bleed or Not?
You may want to see also
Explore related products

Filtration Process: Use filters to remove debris and isolate pure spores
The filtration process is a critical step in purifying spores from mushrooms, as it effectively removes debris and isolates the desired spores. Begin by preparing a spore suspension, typically obtained by gently rinsing the mushroom cap with sterile water or a specialized spore collection solution. This initial rinse captures the spores but also includes unwanted particles like soil, hyphae, and other contaminants. To initiate filtration, assemble a sterile setup using a vacuum filtration apparatus or a simple funnel with filter paper. Ensure all equipment is sterilized to prevent contamination. Place a filter with an appropriate pore size—usually between 10 to 20 micrometers—to capture debris while allowing spores to pass through.
Once the filtration setup is ready, carefully pour the spore suspension onto the filter. Apply gentle vacuum pressure or allow gravity to draw the liquid through the filter. This step separates larger debris, such as mushroom tissue fragments and soil particles, which remain on the filter surface. The filtrate collected below will contain a higher concentration of spores with significantly reduced contaminants. For enhanced purity, consider using a series of filters with decreasing pore sizes, starting with a coarser filter to remove larger particles and ending with a finer filter to capture smaller debris.
After the initial filtration, the filtrate may still contain microscopic contaminants. To further purify the spores, transfer the filtrate to a new sterile container and repeat the filtration process using a 5-micrometer filter. This finer filtration ensures that only spores and very small particles remain in the solution. If additional purity is required, centrifugation can be employed to pellet the spores, followed by discarding the supernatant and resuspending the spores in sterile water or a suitable medium.
For advanced applications, such as laboratory research or commercial spore production, membrane filters with precise pore sizes can be used. These filters are often made of materials like cellulose acetate or polycarbonate and provide consistent results. Ensure the filters are compatible with the spore suspension to avoid clogging or damage. After filtration, inspect the filtrate under a microscope to confirm the presence of pure spores and the absence of significant contaminants.
Finally, store the purified spore suspension in a sterile container, such as a glass vial, and keep it in a cool, dark place to maintain viability. Proper labeling with the mushroom species, date of purification, and filtration details is essential for record-keeping and future use. The filtration process, when executed meticulously, yields a high-purity spore solution suitable for cultivation, research, or preservation, ensuring successful and uncontaminated mushroom growth in subsequent stages.
Should You Peel White Button Mushrooms?
You may want to see also

Chemical Treatment: Apply sterilizing agents to eliminate bacteria and fungi from spore samples
Chemical treatment is a critical step in purifying mushroom spores, as it effectively eliminates bacteria, fungi, and other contaminants that can compromise the integrity of the spore sample. One of the most commonly used sterilizing agents is hydrogen peroxide (H₂O₂), typically at a concentration of 3% to 10%. To apply this method, mix the spore sample with hydrogen peroxide and allow it to sit for 10 to 20 minutes. Hydrogen peroxide works by oxidizing cellular components of contaminants, effectively killing them. After treatment, it is essential to neutralize the hydrogen peroxide to prevent damage to the spores. This can be done by adding a reducing agent like sodium thiosulfate or simply diluting the solution with sterile water.
Another effective chemical treatment involves using sodium hypochlorite (bleach), typically diluted to a concentration of 1% to 2%. Bleach is a powerful oxidizing agent that rapidly destroys bacteria and fungi. To treat the spore sample, mix it with the diluted bleach solution and let it stand for 5 to 10 minutes. Afterward, thoroughly rinse the spores with sterile water to remove any residual bleach, as it can be harmful to the spores if left untreated. This method is highly effective but requires careful handling due to the corrosive nature of bleach.
Ethanol is another sterilizing agent commonly used in spore purification. A concentration of 70% ethanol is ideal, as it effectively kills contaminants without denaturing the spore proteins. Submerge the spore sample in ethanol for 1 to 2 minutes, then remove and allow it to air dry in a sterile environment. Ethanol evaporates quickly, leaving behind purified spores. This method is straightforward but requires precision to avoid overexposure, which could damage the spores.
For more specialized applications, merthiolate (thimerosal) can be used as a sterilizing agent. Dilute merthiolate to a concentration of 0.1% and mix it with the spore sample for 5 to 10 minutes. Merthiolate is particularly effective against bacteria and fungi but must be neutralized with sterile water or a neutralizing agent afterward. This method is less commonly used due to its potential toxicity but can be highly effective when other methods fail.
Regardless of the chemical treatment chosen, it is crucial to work in a sterile environment to prevent recontamination. Use sterile tools, containers, and techniques such as flame sterilization to ensure the purity of the spore sample. After chemical treatment, the spores should be rinsed multiple times with sterile water to remove any residual chemicals. Finally, store the purified spores in a sterile container at an appropriate temperature to maintain their viability for future use.
Maitake Mushrooms: Are They Safe to Eat?
You may want to see also
Frequently asked questions
Purifying spores ensures a clean, uncontaminated sample for cultivation, research, or preservation, reducing the risk of unwanted bacteria, fungi, or debris interfering with growth or analysis.
You’ll need a sterile scalpel or needle, sterile water or spore syringe solution, a sterile container (e.g., petri dish or agar plate), a flame source (e.g., alcohol lamp), and a microscope (optional for verification).
Place the mushroom cap gill-side down on a sterile surface (e.g., foil or glass slide). Cover it with a container to prevent contamination and let the spores drop naturally. Alternatively, gently scrape the gills with a sterile tool.
Use an open flame (e.g., alcohol lamp) to flame-sterilize tools like scalpels or needles. For containers, autoclave or use pre-sterilized labware. Ensure all surfaces are clean and work in a sterile environment.
Examine the spores under a microscope to check for contaminants. Alternatively, inoculate a sterile agar plate with the spore solution and observe for unwanted growth. Pure spores should produce consistent, uncontaminated colonies.

























